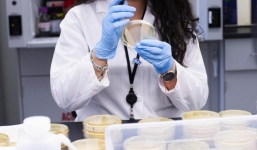
Các tổ chức nghiên cứu Covid-19 của Mỹ bị tin tặc nước ngoài tấn công

Tin tức thế giới 24h ngày 17/4: Dịch Covid-19, kinh tế Trung Quốc suy sụp
17-04-2020 | 11:59
Cập nhật tin tức thế giới 24h mới nhất ngày 17/4/2020: Kinh tế Trung Quốc suy thoái, Brazil sa thải Bộ trưởng Y tế...

17-04-2020 | 11:34
Con gái trùm ma túy khét tiếng nhất Mexico đi viện trợ Covid-19

17-04-2020 | 11:30
Tìm ra nhiệt độ khiến virus corona bị tiêu diệt hoàn toàn

17-04-2020 | 11:02
Tổng thống Brazil sa thải Bộ trưởng Y tế ngay trước đỉnh dịch

17-04-2020 | 10:40
Tổng thống Putin ca ngợi Trung Quốc đối phó dịch hiệu quả

17-04-2020 | 10:29
Ấn Độ phát hiện 50.000 bộ bảo hộ y tế Trung Quốc tặng không đạt tiêu chuẩn
17-04-2020 | 09:35
Các tổ chức nghiên cứu Covid-19 của Mỹ bị tin tặc nước ngoài tấn công

17-04-2020 | 09:07
Số ca mắc Covid-19 ở Nga tăng 4 ngày liên tiếp, 80 người Việt nhiễm

17-04-2020 | 09:02
Ủng hộ Trump, đảng Cộng hòa kêu gọi lãnh đạo WHO từ chức

16-04-2020 | 22:11
Thủ tướng Nhật Bản tuyên bố tình trạng khẩn cấp trên toàn quốc

16-04-2020 | 18:13
Hàn Quốc: Hơn 140 bệnh nhân Covid-19 hồi phục dương tính trở lại

16-04-2020 | 17:50
Thanh niên nhét bạn vào vali để trốn cách ly bất chấp lệnh phong tỏa

16-04-2020 | 17:48
Xét nghiệm sàng lọc Covid-19 ngay trước khi lên máy bay

16-04-2020 | 17:29
Số người chết của Mỹ quá lớn, Trump nghi nhiều nước đang nói dối

16-04-2020 | 16:49
Trung Quốc lên tiếng về kịch bản Covid-19 bị rò rỉ từ phòng thí nghiệm

16-04-2020 | 15:12
Kim Jong-un và động thái chưa từng có từ khi lên nắm quyền

16-04-2020 | 14:35
WHO đã làm những gì trong đại dịch Covid-19?

16-04-2020 | 11:46
Tin tức thế giới 24h ngày 16/4: Vắc xin Covid-19, Mỹ tuyên bố qua đỉnh dịch

16-04-2020 | 11:15
3 nhà báo đưa tin Covid-19 ở Vũ Hán vẫn 'mất tích'

16-04-2020 | 10:17
Mỹ điều tra giả thuyết Covid-19 bắt nguồn từ phòng thí nghiệm Vũ Hán

16-04-2020 | 09:36
Covid-19 khiến châu Á tăng trưởng 'què quặt' sau 60 năm

16-04-2020 | 08:59
LHQ: Vắc xin Covid-19 là cách duy nhất để thế giới trở lại bình thường

16-04-2020 | 08:07
Ca tử vong vì Covid-19 vượt 30.000, TT Trump tuyên bố Mỹ đã 'qua đỉnh dịch'

15-04-2020 | 19:55
WHO: 70 loại vắc-xin đang được phát triển để chống Covid-19

15-04-2020 | 18:28
Hàng trăm người biểu tình khi Ấn Độ gia hạn phong tỏa toàn quốc

15-04-2020 | 17:53
Bộ Ngoại giao Mỹ cảnh báo về phòng thí nghiệm virus Vũ Hán từ 2 năm trước

15-04-2020 | 17:25
Chuyên gia WHO: Mỹ và châu Âu có thể thêm 3 đợt bùng phát Covid-19

15-04-2020 | 16:41
Trung Quốc 'quan ngại' khi Mỹ rút tiền tài trợ WHO

15-04-2020 | 16:07


